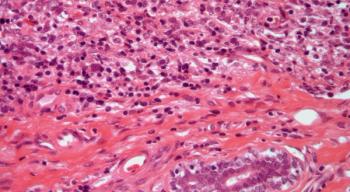
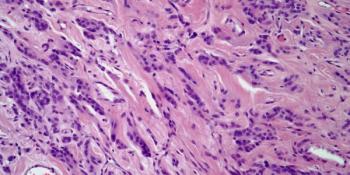
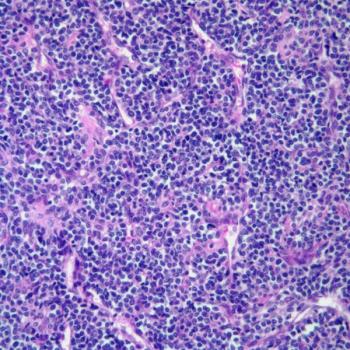

A 38-year-old woman presents with abdominal pain, and a biopsy is performed. What is your diagnosis?

Your AI-Trained Oncology Knowledge Connection!


A 38-year-old woman presents with abdominal pain, and a biopsy is performed. What is your diagnosis?

A 27-year-old immigrant from Africa presents with a hypopigmented arm lesion, and a biopsy is obtained. What is your diagnosis?
A 52-year-old woman develops a mass in her left breast, and a biopsy is performed. What is your diagnosis?

A 14-year-old girl presents with a soft-tissue mass at the level of the cauda equina. Based on the image shown, what is your diagnosis?

A 43-year-old woman presents with a tumor in the uterus, and a biopsy is obtained. What is your diagnosis?

A 38-year-old woman develops a mass in her right breast, and a biopsy is obtained. What is your diagnosis?

A 56-year-old woman presents with a skin mass on her right leg, and a biopsy is obtained. What is your diagnosis?

A 43-year-old man presents with a thyroid nodule, and a biopsy is performed. What is your diagnosis?

A 32-year-old woman, who had recently delivered a baby, develops a nodule in her left breast. A biopsy is obtained. What is your diagnosis?



A 49-year-old woman develops a mass in her right breast, and a biopsy is obtained. What is your diagnosis?

A 12-year-old girl presents with a vaginal mass, and a biopsy is obtained. What is your diagnosis?

A 21-year-old woman develops a nodule in her left breast, and a biopsy is obtained. What your diagnosis?

A 48-year-old man presents with a skin mass on his left shoulder, and a biopsy is performed. What is your diagnosis?

A 43-year-old woman develops a mass in her left breast, and a biopsy is obtained. What is your diagnosis?

A 37-year-old woman presents with a small nodule in her right breast, and a biopsy is obtained. What is your diagnosis?
A 28-year-old woman presents with a vulvar mass, and a biopsy is obtained. What is your diagnosis?

A 67-year-old man presents with a mass in his right thigh, and a biopsy is performed. What is your diagnosis?

A 60-year-old woman presents with an ovarian tumor, and a biopsy is obtained. What is your diagnosis?

A 48-year-old woman presents with a mass in her right breast, and a biopsy is obtained. What is your diagnosis?

A 38-year-old man presents with a fever and headaches. A brain mass is detected, and a biopsy is obtained. What is your diagnosis?

A 44-year-old man presents with a lesion on his right upper back, and a biopsy is performed. What is your diagnosis?

A 34-year-old woman presents with a lesion in the salivary gland, and a biopsy is obtained. What is your diagnosis?

A 57-year-old man presents with hematuria, and a bladder biopsy is obtained. What is your diagnosis?
A 52-year-old man presents with a lesion of the lower back, and a biopsy is performed. What is your diagnosis?

A 38-year-old woman presents with a lesion in the pancreas, and a biopsy is obtained. What is your diagnosis?

A 68-year-old man presents with dysuria and hematuria, and a bladder biopsy is obtained. What is your diagnosis?

A 54-year-old man presents with a lesion in the brain, and a biopsy is performed. What is your diagnosis?

A 54-year-old woman presents with a mass in the vagina, and a biopsy is performed. What is your diagnosis?